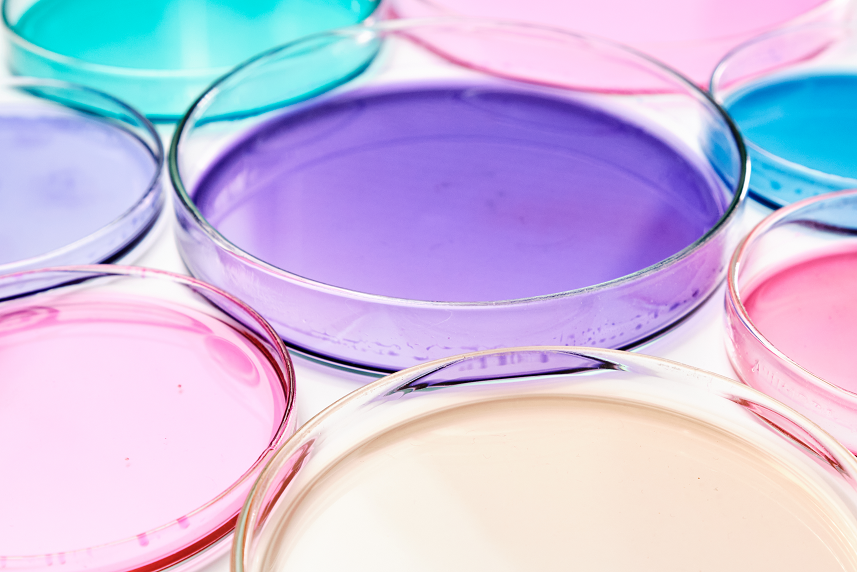
Olie

Microbial Regulators
The worldwide reduction of antibiotic growth promoters (AGP) in animal feed, and ultimate ban, does not come without challenges. High performing animals require optimal intestinal health and immunity to reach their true potential. Consequently, even the slightest intestinal imbalance can compromise production performance. As such, alternative approaches for supporting livestock production are necessary.
Since the late 1990’s, Palital has collaborated with universities and research centers to investigate and develop concepts for our AveMix® Microbial Regulators range. The different product concepts within the range enable the challenges associated with the reduction of AGP use in animal feed to be addressed.
